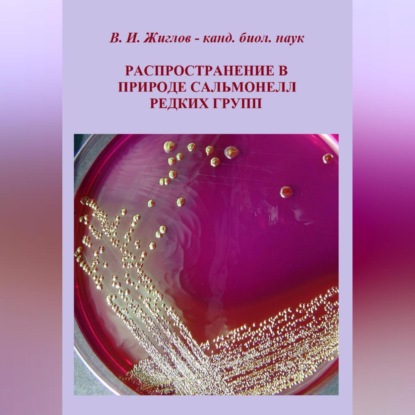

Распространение в природе сальмонелл редких групп

Издательство:
SelfPub
Сальмонеллез – это серьезная проблема общественного здравоохранения, вызывающая ежегодно миллионы заболеваний и смертей по всему миру. Несмотря на значительные усилия по контролю и профилактике, заболеваемость сальмонеллезом продолжает расти, что обусловлено рядом факторов. Изучение распространения редких групп сальмонелл имеет ключевое значение для разработки эффективных мер по профилактике и лечению сальмонеллеза. Недостаточная изученность этих серотипов создает серьезные вызовы для общественного здравоохранения.